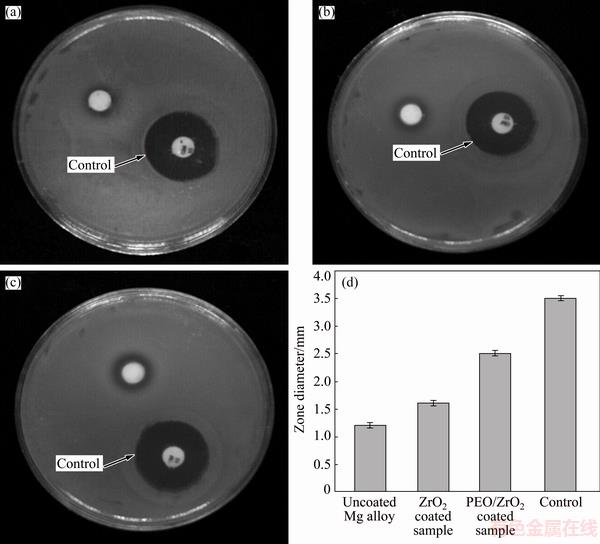

Trans. Nonferrous Met. Soc. China 28(2018) 1571-1581
Antibacterial activities and corrosion behavior of novel PEO/nanostructured ZrO2 coating on Mg alloy
Mohammadreza DAROONPARVAR1,2, Muhamad Azizi MAT YAJID1, Rajeev KUMAR GUPTA2, Noordin MOHD YUSOF1, Hamid Reza BAKHSHESHI-RAD1,3, Hamidreza GHANDVAR1, Ehsan GHASEMI4
1. Department of Materials, Manufacturing and Industrial Engineering, Faculty of Mechanical Engineering, Universiti Teknologi Malaysia, 81310 Johor Bahru, Johor, Malaysia;
2. Department of Chemical and Biomilecular Engineering, Corrosion Engineering Program, The University of Akron, Akron, OH-44325, United States of America;
3. Advanced Materials Research Center, Department of Materials Engineering, Najafabad Branch, Islamic Azad University, Najafabad, Iran;
4. Department of Clinical Sciences, Faculty of Veterinary Medicine, University of Tehran, Tehran, Iran
Received 4 June 2017; accepted 23 October 2017
Abstract:
Plasma electrolytic oxidation (PEO) was developed as a bond coat for air plasma sprayed (APS) nanostructure ZrO2 as top coat to enhance the corrosion resistance and antibacterial activity of Mg alloy. Corrosion behavior and antibacterial activities of coated and uncoated samples were assessed by electrochemical tests and agar diffusion method toward Escherichia coli (E. coli) bacterial pathogens, respectively. The lowest corrosion current density and the highest charge transfer resistance, phase angle and impedance modulus were observed for PEO/nano-ZrO2 coated sample compared with those of PEO coated and bare Mg alloys. Nano-ZrO2 top coat which has completely sealed PEO bond coat is able to considerably delay aggressive ions transportation towards Mg alloy surface and significantly enhances corrosion resistance of Mg alloy in simulated body fluid (SBF) solution. Moreover, higher antibacterial activity was also observed in PEO/nano-ZrO2 coating against bacterial strains than that of the PEO coated and bare Mg alloys. This observation was attributed to the presence of ZrO2 nanoparticles which decelerate E. coli growth as a result of E. coli membranes.
Key words:
Mg alloy; ceramics; coating materials; microstructure; scanning electron microscopy (SEM);
1 Introduction
High chemical activity and poor corrosion resistance of Mg and its alloys limit their biomedical applications in corrosive environments. Corrosion resistance of Mg and its alloys can substantially be improved by protective coatings. Various conventional coating techniques were used to reduce the surface activity of Mg and its alloys [1-4]. Plasma electrolytic oxidation (PEO) method is considered as an eco-friendly method to produce hard ceramic complex coatings with inert ceramic-like composition, excellent bond strength and relatively high thickness on metal substrates [5-7]. However, coatings which have been made by the PEO method are generally porous and include many micro-defects. These defects are able to reduce the surface quality of PEO coatings and can easily conduct electrolyte towards alloy surface during corrosion [8]. Hence, some post-treatments should be performed to seal the micro-pores of PEO coatings and increase their protection performance [9-12]. However, some sealing coatings (such as sol-gel, organic, conversion, polymer coatings) showed undesirable mechanical properties and considerable micro-defects which originated from solvent vaporization or insufficient filling of PEO micro-pores due to the presence of air in these pores [9].
Recently, corrosion, oxidation and wear resistances of magnesium alloys have considerably been increased by plasma sprayed multilayer coatings including ceramic top coatings and metallic bond coating (such as NiCrAlY bond coat) [13-18]. However, there is high standard electrochemical potential difference between the metallic bond coat (as noble coating) and Mg alloy (as anode).
Once, electrolyte reaches Mg alloy/NiCrAlY bond coat (as non-biocompatible coat) interface, a sever galvanic cell can be formed at this interface which eventually leads to the coating separation from the substrate [4,14,16-18]. Hence, it is predicted that PEO as a biocompatible ceramic bond coat could supply dockage locations for molten ceramic droplets during plasma spraying and could considerably reduce the galvanic cell formation between coating and Mg alloy during corrosion. In this vision, air plasma spraying which is a low cost and straightforward method [19-22] will be used for spraying nano-ZrO2 coating as sealing top coat on PEO inert bond layer. Nanostructured ZrO2 coating consisting of bimodal structure and non-transformable tetragonal ZrO2 phases showed bioactivity in SBF solution [23]. However, a study on the corrosion behavior and antibacterial properties of PEO/ nanostructured ZrO2 coating on biodegradable Mg alloy could not be found in the literature. Hence, in the present research, microstructure, corrosion behavior and antibacterial activities of PEO coated Mg alloy and PEO/nanostructured ZrO2 coated Mg alloy were explored.
2 Experimental
2.1 Preparation of specimens for PEO and APS processes
Mg alloy (0.018% Si, 0.021% Mn, 0.008% Al, 0.011% Fe, 1.008% Ca and Mg balance) cylindrical ingot with diameter of 25 mm and length of 200 mm was cut out to specimens with dimensions of 15 mm ��15 mm �� 6 mm. The composition of PEO mixture electrolyte comprised 2 g/L KOH, 13 g/L Na2SiO3 and 7 g/L NaAlO2, which was freshly prepared and swiftly used for PEO process. On the other hand, a stainless steel plate with dimensions of 60 mm �� 120 mm �� 2 mm was employed as a counter electrode. The current density was maintained at 2 A/cm2. Moreover, the applied voltage and preparation time were 350 V and 10 min, respectively for this PEO process. The temperature of the electrolyte was kept at 15-20 ��C by a water cooling system. The duty cycle of pulsed DC power supply unit was 60%. In the meantime, a relatively high pulse frequency of 1000 Hz was chosen for this process.
Granulated nanostructure ZrO2 powders [24-26] (plasma spray-able agglomerated micro-meter sized granules) were successfully prepared and deposited on the PEO coated samples using air plasma spray system (3 MB gun, Sulzer Metco) with the aid of compressed air during plasma spraying and optimized APS parameters [4,16,17,26].
2.2 Characterization, electrochemical measurements and antibacterial activity test
The surface morphology and cross section of the coated Mg alloys were seen under Hitachi S4160 field emission scanning electron microscopy machine. In the meantime, elemental analysis of the coated samples was performed by energy dispersive spectroscopy (EDS) method. Moreover, low-angle X-ray diffraction (XRD with Cu K�� radiation, Rigaku D, Japan) was used to do phase analysis of treated and untreated Mg samples in 2�� (diffraction angle) range of 20��-90��.
Potentiodynamic polarization test was performed using a PARSTAT 2263 advanced electrochemical system in SBF solution at a scan rate of 1.0 mV/s (at room temperature). A saturated calomel electrode (SCE) as the reference electrode, a platinum rod as the counter electrode and the sample as the working electrode formed the electrochemical cell. Moreover, the exposure area was 1 cm2. On the other hand, for the electrochemical impedance spectrum (EIS) test, scan frequency ranged from 1 Hz to 105 Hz with perturbation amplitude of 5 mV.
The antibacterial activity of the uncoated and coated samples against Escherichia coli PTCC 1330 (Gram- negative) bacteria was examined according to the disc diffusion antibiotic sensitivity [27]. In the present study, gentamicin discs for bacteria (10 ��g/disc) were used as reference.
3 Results and discussion
3.1 Microstructural characterization of PEO and multilayered coatings on Mg alloy
Figure 1(a) demonstrates the cross-section morphology of PEO coated Mg alloy. There is a good integrity between multiphase composite PEO coating ((15��1) ��m in thickness) and Mg alloy substrate. This integrity originated from the sintered interlocking during PEO process. PEO film generally shows a duplex structure consisting of an outer layer which is porous and an inner barrier layer which is completely dense [28,29].
Vertical micro pores which are present in the outer porous layer of PEO coating are internally obstructed by dense inner barrier layer of PEO coating (see Figs. 1(a), 1(b) and 2(a)). This phenomenon can be ascribed to the pores in the PEO layer which always give birth to discharge during coating process [30]. Moreover, higher pores density on the outer porous layer would lead to the increment of effective surface area of the PEO coating. Hence, corrosive solution can increasingly be adsorbed by the micro-pores of outer porous layer and can quickly infiltrate into the inner barrier layer. This phenomenon would eventually lead to the galvanic cell formation between Mg alloy and corrosive solution. It is interesting to note that sparking discharge, gas bubble and the considerably low Pilling�CBedworth (PB) ratio of Mg oxide to Mg substrate (about 0.81) would lead to the formation of micro-pores in the PEO coatings [9,31]. Hence, it is expected that corrosion resistance of PEO coated Mg alloy could be increased by sealing micro-pores of outer porous layer. This expectation could be performed by spraying nanostructured granulated ZrO2 coating on multiphase PEO coating (as bond coat).

Fig. 1 Cross-section FESEM image of PEO treated Mg alloy (a), surface morphology of PEO bond layer (high magnification) (b), and cross-section FESEM image of PEO/nanostructured ZrO2 coated Mg alloy (c)

Fig. 2 Surface morphology of multiphase PEO coating (low magnification) (a) and surface morphologies of nanostructured ZrO2 coating with compact and bimodal structure (b-f)
Figure 1(c) indicates the cross-section morphology of PEO/nanostructured ZrO2 coating ((60��5) ��m in thickness) on Mg alloy. This system (coating) including inner barrier layer, outer porous layer and nanostructured ZrO2 layer is still bonded with Mg alloy after sever grinding and polishing for cross section characterization. Hence, it is speculated that there is suitable adhesion between coatings and Mg alloy.
There is nearly clear interface between the nanostructured ZrO2 layer and multiphase PEO layer which indicates physical interlocking (integrity) between bond coat and nanostructured ZrO2 layer (as top coat). This observation could be ascribed to the infiltration of molten ZrO2 particles into the outer porous layer of PEO coating and followed by elimination of present air in the micro-pores during air plasma spraying (see Fig. 3(a)). Hence, nanostructured ZrO2 coating is able to considerably seal multiphase PEO layer.
As previously stated, Mg alloy surface (with high activity) can severely be oxidized under the direct effect of plasma flame (with high temperature). Moreover, thermal expansion coefficient (TEC) mismatch between ceramic coatings and Mg alloy was found to be very high. These phenomena led to the premature spallation of plasma sprayed ceramic coating from Mg surface after spraying process [14]. However, in this work, TEC mismatch between ZrO2 coating (7��10-6-8��10-6 K-1) and Mg alloy (26��10-6 K-1) was significantly reduced by using an inert multiphase PEO layer (MgO: 12.6��10-6 K-1, MgAl2O4: 7.5��10-6 K-1, MgSiO2: 6.5��10-6 K-1) as bond coat [13,32,33]. Hence, slightly thick multiphase PEO layer could be able to preserve Mg surface from sever oxidation during APS (with the aid of compressed air) and would prevent sprayed ceramic coating detachment from Mg alloy after spraying and its cooling down to ambient temperature (see Fig. 1(c)).
Figures 1(b) and 2(a) indicate surface morphology of PEO layer which is rough and porous. It is assumed that outer porous layer of PEO coating could supply dockage locations for molten ZrO2 droplets during plasma spraying.
Nanostructured ZrO2 coating surface (Fig. 2(b)) showed less pinholes, voids and micro-cracks compared to PEO layer (Fig. 2(a)). This case is mainly related to the compactness of the nanostructure [34-39]. Plasma sprayed nanostructure ZrO2 coating showed a bi-model structure (see Figs. 2(b)-(f)) which was also observed by the previous investigators [14,17,24]. This structure includes partially/none molten regions (nano-regions (A)) (Figs. 2(e) and 2(f)) which are surrounded by fully molten regions (Figs. 2(b), 2(c)(B) and 2(d)). Thus, it is predicted that nanostructured ZrO2 coating with bi-model and nearly compact structure could remarkably enhance the corrosion resistance and biocompatibility of multiphase PEO coated Mg alloy in SBF solution. It was reported that the presence of nano-regions on the coating surface would lead to the increment of biocompatibility of biomaterials [13,23,35].

Fig. 3 EDX mapping from cross section of multilayered PEO/nanostructured ZrO2 coated Mg alloy (a-f), EDX area from PEO layer surface (g) and from ZrO2 layer surface (h)
The existence of Zr and O elements in the ZrO2 coating and also the presence of Si, Al, Mg and O elements in the multiphase PEO layer as well as attendance of Mg and Ca elements in Mg-1%Ca alloy can easily be observed in the EDX mapping (see Figs. 3(a)-(f)) from cross section of multilayered coated Mg alloy. Moreover, the EDX area from surface of coatings proved the presence of Zr and O elements in the ZrO2 coating and also the existence of Si, Al, Mg and O elements in the multiphase PEO layer (see Figs. 3(g) and (h)).
Figures 4(a)-(d) demonstrate XRD patterns of bare Mg alloy, multiphase PEO layer, granulated ZrO2 powders and nanostructured ZrO2 layer, respectively. Figure 4(a) shows that the main phase of the alloy is ��-Mg with hexagonal close packed (HCP) crystalline structure. However, Mg2Ca phase was not identified, which is consistent with the previous studies [40]. In fact, Mg2Ca phase with HCP crystalline structure has a space group of P63/mmc and the lattice parameters of a= 0.623 nm and c=1.012 nm. But, the size of the lattice parameters of this phase is two times larger than that of ��-Mg phase [41].

Fig. 4 XRD patterns of bare Mg alloy (a), multiphase PEO layer (b), granulated ZrO2 powders (c) and nanostructured ZrO2 layer (d)
The XRD pattern of the PEO coated Mg alloy (Fig. 4(b)) depicts that PEO coating is largely constituted by ��-Mg, MgAl2O4, MgO and Mg2SiO4 phases. The existence of ��-Mg peaks (in XRD pattern of PEO coated sample) which have likely been extracted from Mg alloy surface originated from low thickness and loose microstructure of the PEO coatings. It is obviously seen that the produced coating is crystalline in nature. This observation may be related to the clear sharpness of all the diffracted peaks.
Figure 4(c) shows that nanostructured ZrO2 agglomerated powder is largely constituted by only non-transformable tetragonal phase. Figure 4(d) obviously indicates that nanostructured ZrO2 layer is mainly composed of non-transformable tetragonal ZrO2 phase which could originate from rapid solidification (quenching of the molten droplets) during air plasma spraying [34]. It is interesting to note that cooling rate of splats was reported to be 107 ��C/s during APS process [36].
Vickers hardness tester (HVS-10) was employed to measure micro-hardness of treated and untreated samples. This test was performed on the polished cross section of treated Mg alloys (from coating surface to the interface of Mg alloy/coating) at ten different places under a load of 150 g for 15 s and the average value was demonstrated (Fig. 5). Micro-hardness of Mg alloy is measured to be only HV 77.9. It is apparent that multiphase PEO coating is substantially able to develop micro-hardness of Mg alloy substrate (HV 300.5). Hence, inert multiphase PEO bond coat (with nearly rough surface) could afford needed micro-hardness for Mg alloy substrate to integrate with nanostructured ZrO2 layer which could substantially increase the hardness to HV 740. It is expected that PEO/nanostructured ZrO2 coating could remarkably enhance mechanical properties of the substrate.

Fig. 5 Micro-hardness of coated and uncoated Mg alloys
3.2 Electrochemical measurement
Figure 6 depicts the anodic and cathodic polarization curves of bare Mg alloy, multiphase PEO coated Mg alloy and PEO/nano-ZrO2 coated Mg alloy in the SBF solution. The corrosion potentials (��corr vs SCE) of untreated Mg alloy, PEO coated Mg alloy and PEO/nanostructured ZrO2 coated Mg alloy are -1601, -1148 and -912 mV, respectively. Thus, it is expected that Mg dissolution could remarkably be diminished by the PEO/nano-ZrO2 coating with more positive corrosion potential.

Fig. 6 Anodic and cathodic polarization curves of bare Mg alloy, multiphase PEO coated Mg alloy and multilayered PEO/nano-ZrO2 coated Mg alloy in SBF solution
It is visible that multiphase PEO coating has ability to decline the corrosion current density (Jcorr) of substrate to 0.21 ��A/cm2 which is lower than Jcorr of uncoated Mg alloy substrate (280.4 ��A/cm2). This statement has a direct relationship with inert nature and microstructure of the PEO coatings which can generally slow the transportation rate of the electrolyte in the PEO coated samples during corrosion. This phenomenon can mostly lessen Jcorr of PEO coated sample in aggressive electrolyte. However, Jcorr of PEO/ nanostructured ZrO2 coated sample was noticeably declined to 0.062 ��A/cm2. In fact, the diffusion (penetration) of aggressive electrolyte (corrosive ions from the SBF solution) into the Mg alloy surface can substantially be postponed and suppressed by applying a compact, more uniform and slightly thicker PEO/ nanostructured ZrO2 coating on metallic substrate. However, it is interesting to point out that single multiphase PEO layer (composed of stable oxide phases, particularly Mg2SiO4 phase) is not able to substantially preserve Mg alloy in SBF solution. This case is mainly related to the microstructural characteristics of the PEO coatings. Hence, nanostructured ZrO2 coating (as top coat) on the multiphase PEO layer (as bond coat) would be able to considerably increase the corrosion protection performance of PEO layer on Mg alloy in physiological solutions. This multiphase PEO layer is able to preserve Mg alloy from aggressive ion when it permits through from nanostructured ZrO2 top coat during corrosion.
Figures 7 and 8 demonstrate the EIS data (Nyquist and Bode plots) for the coated Mg alloys as well as bare Mg alloy in SBF solution. It is easily seen that both treated and untreated samples demonstrate a single capacitive loop at all high frequencies (Figs. 7(a) and (b)). This observed behavior was also seen in Mg samples coated with MAO/Ni-P coating and other types of multilayered coatings which also depicted one capacitive loop in their Nyquist curve although they had two or more layers [37-45]. However, single multiphase PEO coating and PEO/nano-ZrO2 coating showed bigger diameter of capacitive loop compared with the bare Mg alloy.

Fig. 7 EIS data (Nyquist plots) for coated Mg alloys as well as bare Mg alloy in SBF solution

Fig. 8 EIS data (Bode plots) for coated Mg alloys as well as bare Mg alloy in SBF solution
It was reported that charge transfer resistance can ascertain the corrosion resistance of sample. Moreover, there was a direct relationship between charge transfer resistance and the diameter of the capacitive loop of Nyquist curve. Hence, preferable corrosion resistance of coated sample is in a direct connection with its greater charge transfer resistance and bigger diameter of its capacitive loop compared with those of uncoated sample [46,47]. Thus, charge transfer resistance (Rct) of PEO/nano-ZrO2 coated Mg alloy (30.830 k����cm2) is higher than that of multiphase PEO coated Mg alloy (19.941 k����cm2) and uncoated Mg alloy (1.124 k����cm2). In fact, excellent corrosion resistance of PEO/nano-ZrO2 coating could be affected by low solubility, higher thickness and compactness of ZrO2 coating as well as good corrosion resistance of multiphase PEO coating (as bond coat) on Mg alloy.
Bode magnitude plots and Bode phase plots are shown in Figs. 8(a) and (b), respectively. It is clearly seen that there is a direct relationship between impedance modulus (Z) at lower frequency (Fig. 8(a)) and charge transfer resistance (Rct). This statement is in agreement with the previous investigations [48-50]. It is easily observed that impedance modulus of PEO/nano-ZrO2 coated Mg alloy has noticeably been increased compared with Z of other samples at lower frequency (Fig. 8(a)). It was reported that phase angle and its broadening are two factors that can also distinguish corrosion protective performance of the coatings [51,52]. The lowest and the highest values were found for untreated sample and PEO/ZrO2 coated sample, respectively (Fig. 8(b)). These lowest values may be related to the ultrathin formed oxide films (nanometric films) on bare Mg alloys which are very susceptible to the corrosive medias [46,53]. Hence, PEO/nano-ZrO2 coating with the lowest anodic current density and the highest values of EIS data (Rct, Z, phase angle) can effectively enhance the corrosion resistance of Mg alloy in physiological solutions. In fact, nano-ZrO2 top coat can effectively seal PEO micro-defects and obstructing the transportation of corrosive ions in the PEO bond coat and followed by galvanic cell formation at the coating/Mg alloy interface [54,55]. According to these obtained results, the elaboration of corrosion process could be suggested by the following mechanism. Mg(OH)2 formation can be expected at the PEO/Mg alloy interface (when electrolyte reaches interface of PEO/substrate through micro-pores in the coating) at the onset of corrosion. Dissolution and restructuring of Mg(OH)2 can also be anticipated at the interface (freshly Mg surface) in this stage (see Fig. 9). Moreover, MgCl2 formation (substituting OH- by Cl-) with high solubility may locally dissolve the surface film and exposes freshly Mg surface to be re-corroded [6]. Mg dissolution followed by hydrogen formation (evolution) which could apply pressures on PEO layer and causes micro-cracks formation and coating separation are predicted in the subsequent stage [40,41,49,56]. However, nano-ZrO2 top coat (with bimodal and compact structure [57]) which has completely sealed PEO bond coat is able to considerably prevent and delay aggressive ions transportation [58] (Fig. 9). Hence, PEO/nano-ZrO2 coating can be considered as a good candidate to substantially enhance corrosion resistance of Mg alloy in the SBF solution.

Fig. 9 Schematic illustration of electrochemical corrosion mechanism of multilayered PEO/nanostructured ZrO2 coated Mg alloy in simulated body fluid solution
3.3 Antibacterial activities of bare Mg alloy, PEO and PEO/nano-ZrO2 coated Mg alloy
The antibacterial activities of the bare Mg alloy, multiphase PEO coated Mg alloy and PEO/nano-ZrO2 coated Mg alloy were tested for Escherichia coli (Gram negative) bacteria via disc diffusion method (see Fig. 10). Less significant zone of inhibition can be detected under contact with bare Mg alloy. The inhibition zone diameter increases after PEO and PEO/nano-ZrO2 coatings which indicated high antibacterial activity toward E. coli. The size of the inhibition zone was in the range of 2.5 mm for the PEO/nano-ZrO2 coated samples whereas zones of inhibition was in the range of 1.6-1.2 mm for PEO coated and bare Mg alloy samples, respectively. Formation of a clear inhibition zone in the areas surrounding the surface of PEO/nano-ZrO2 coated Mg alloy further confirmed that the specimens have a great antibacterial activity against E. coli. Regarding antibacterial activity of multiphase PEO coated Mg alloy, the existence of micro-pores and micro-cracks on the surface of PEO layer, leading to the exposure of Mg substrate to the bacterial medium and thus maintaining its antibacterial performance because of its degradation and subsequent escalation in the pH value [59]. However, the main reason of good antibacterial performance of PEO/nano-ZrO2 coated sample is attributed to the presence of ZrO2 nanoparticles which decelerate E. coli growth as a result of E. coli membranes and thus escalate membrane permeability resulted in deposition of nanoparticles in the bacterial membrane and cytoplasmic areas of the cells [60].
Fig. 10 Inhibition zones of uncoated Mg alloy (a), PEO coated (b), PEO/nanostructured ZrO2 coated samples (c) and growth inhibition zones of uncoated and coated samples against E. coli bacteria for 24 h (d)
4 Conclusions
The results depict that nanostructured ZrO2 top coat can easily be applied on the multiphase PEO (as bond coat) coated Mg alloy using APS method with the aid of compressed air. This case would lead to the considerable decrease in corrosion current density from 280.4 ��A/cm2, for bare Mg alloy to 0.062 ��A/cm2 for the multilayered coating. In comparison with single multiphase PEO bond coat, the PEO/nanostructured ZrO2 coating shows higher charge transfer resistant (Rct), impedance modulus (Z) and phase angle. Antimicrobial study exhibits that multi-phase PEO coated and PEO/nano-ZrO2 coated Mg alloys show antibacterial activity, but PEO/nano-ZrO2 coated sample presents better activity against E. coli. Nano-ZrO2 top coat which has completely sealed PEO bond coat is able to considerably prevent and delay aggressive ions transportation. Hence, PEO/nano-ZrO2 coating can be considered as a good candidate to substantially enhance corrosion resistance of bio- degradable Mg alloy in SBF solution.
Acknowledgments
The authors would like to acknowledge the Universiti Teknologi Malaysia (UTM) for providing research facilities and financial support under Grants No: (1) UTM-Research University Grant (RUG) (Q.J130000.2524.16H35), and (2) Nippon Sheet Glass (NSG) R.J130000.7324.4B300.
References
[1] TSAI W T, SUN I W. Electro-deposition of aluminum on magnesium (Mg) alloys in ionic liquids to improve corrosion resistance [J]. Corrosion Prevention of Magnesium Alloys, 2013: 393-413.
[2] CHIU L H, CHEN C C, YANG C F. Improvement of corrosion properties in an aluminum-sprayed AZ31 magnesium alloy by a post-hot pressing and anodizing treatment [J]. Surface and Coatings Technology, 2005, 191: 181-187.
[3] YUE T M, XIE H, LIN X, YANG H O, MENG G H. Solidification behavior in laser cladding of AlCoCrCuFeNi high-entropy alloy on magnesium substrates [J]. Journal of Alloys and Compounds, 2014, 587: 588-593.
[4] DAROONPARVAR Mohammadreza, YAJID M A M, YUSOF N M, BAKHSHESHI-RAD. Hamidreza, fabrication and properties of triplex NiCrAlY/nano Al2O3��13%TiO2/nano TiO2 coatings on a magnesium alloy by atmospheric plasma spraying method [J]. Journal of Alloys and Compounds, 2015, 645: 450-466.
[5] DAROONPARVAR M, YAJID M A M, YUSOF N M, BAKHSHESHI-RAD. Hamidreza, Preparation and corrosion resistance of a nanocomposite plasma electrolytic oxidation coating on Mg-1%Ca alloy formed in aluminate electrolyte containing titania nano-additives [J]. Journal of Alloys and Compounds, 2016, 688: 841-857.
[6] CUI Xue-jun, YANG Rui-song, LIU Chun-hai, YU Zu-xiao, LIN Xiu-zhou. Structure and corrosion resistance of modified micro-arc oxidation coating on AZ31B magnesium alloy [J]. Transactions of Nonferrous Metals Society of China, 2016, 26: 814-821.
[7] WANG Shu-yan, XIA Yong-ping. Micro arc oxidation coating fabricated on AZ91D Mg alloy in an optimized dual electrolyte [J]. Transactions of Nonferrous Metals Society of China, 2013, 23: 412-419.
[8] BAKHSHESHI-RAD H, HAMZAH E, KAHRIZANGI E, DAROONPARVAR M, MEDRAJ M. Fabrication and characterization of hydrophobic micro arc oxidation/poly-lactic acid duplex coating on biodegradable Mg-Ca alloy for corrosion protection [J]. Vacuum, 2016, 125: 185-188.
[9] FAN Xi-zhi, WANG Ying, ZOU-Bing-lin, GU Li-jian, HUANG Wen-zhi, CAO Xue-qiang. Preparation and corrosion resistance of MAO/Ni-P composite coat on Mg alloy [J]. Applied Surface Science, 2013, 277: 272-280.
[10] SHI P C, NG W F, WONG M H, CHENG F T. Improvement of corrosion resistance of pure magnesium in Hanks�� solution by micro arc oxidation with sol-gel titanium dioxide sealing [J]. Journal of Alloys and Compounds, 2009, 469: 286-292.
[11] RYU Hyun-Sam, PARK Dong-Soo, HONG Seong-Hyeon. Improved corrosion protection of AZ31 magnesium alloy through plasma electrolytic oxidation and aerosol deposition duplex treatment [J]. Surface and Coatings Technology, 2013, 219: 82-87.
[12] ZHAO Quan-ming, GUO Xiong, DANG Qian-xiao, HAO Jian-min, LAI Jiang-hua, WANG Kun-zheng. Preparation and properties of composite MAO/ECD coatings on magnesium alloy [J]. Colloids and Surfaces B: Biointerfaces, 2013,102: 321-326.
[13] LIMA R S, MARPLE B R. Thermal spray coatings engineered from nanostructured ceramic agglomerated powders for structural, thermal barrier and biomedical applications: A review [J]. Journal of Thermal Spray Technology, 2007, 16: 40-63.
[14] FAN Xi-zhi, LIU Yang-jia, XU Zhen-hua, WNG Ying, ZOU Bing-lin, GU Li-jian, WANG Chun-jie, CHEN Xiao-long, KHAN ZS, YANG Dao-wu, CAO Xue-qiang. Preparation and characterization of 8YSZ thermal barrier coatings on rare earth-magnesium alloy [J]. Journal of Thermal Spray Technology, 2011, 20: 948-957.
[15] LI Chong-gui, WANG You, WAN Shi, GUO Li-xin. Laser surface remelting of plasma-sprayed nanostructured Al2O3-13wt%TiO2 coatings on magnesium alloy [J]. Journal of Alloys and Compounds, 2010, 503: 127-132.
[16] FAN Xi-zhi, ZOU Bing-lin, GUA Li-jian, WANGA Chun-jie, WANG Ying, HUANG Wen-zhi, ZHU Ling, CAO Xue-qiang. Investigation of the bond coats for thermal barrier coatings on Mg alloy [J]. Applied Surface Science, 2013, 265: 264-273.
[17] BAKHSHESHI-RAD H, HAMZAH E, ISMAIL A F, DAROONPARVAR M, KASIRI A M, JABBARZARE S, MEDRAJ M. Microstructural, mechanical properties and corrosion behavior of plasma sprayed NiCrAlY/nano-YSZ duplex coating on Mg-1.2Ca-3Zn alloy [J]. Ceramics International, 2015, 41: 15272-15277.
[18] BAKHSHESHI-RAD H, ABDELLAHI A, HAMZAH E, DAROONPARVAR M, RAFIEI M [J]. Introducing a composite coating containing CNTs with good corrosion properties: Characterization and simulation [J]. RSC Advances, 2016, 6: 108498-108512.
[19] DAROONPARVAR M, YAJID M A M, YUSOF N M, BAKHSHESHI-RAD H, Improvement of thermally grown oxide layer in thermal barrier coating systems with nano alumina as third layer [J]. Transactions of Nonferrous Metals Society of China, 2013, 23: 1322-1333.
[20] DAROONPARVAR M, YAJID M A M, YUSOF N M, BAKHSHESHI-RAD H, ESAH H. Effect of Y2O3 stabilized ZrO2 coating with tri-model structure on bi-layered thermally grown oxide evolution in nano thermal barrier coating systems at elevated temperatures [J]. Journal of Rare Earths, 2014, 32: 57-77.
[21] DAROONPARVAR M, YAJID M A M, HUSSAIN M. S, The role of formation of continues thermally grown oxide layer on the nanostructured NiCrAlY bond coat during thermal exposure in air [J]. Applied Surface Science, 2012, 261: 287-297.
[22] DAROONPARVAR M, YAJID M A M, YUSOF N M, BAKHSHESHI-RAD H, HAMZAH E, NAZOKTABAR. Investigation of three steps of hot corrosion process in Y2O3 stabilized ZrO2 coatings including nano zones [J]. Journal of Rare Earths, 2014, 32: 989-1002.
[23] DING C, LIU X. Microstructure and properties of plasma sprayed nano-structural ZrO2 coatings [J]. Nanoelectronics Conference, 2010: 12-13.
[24] YANG Yong, YAN Dian-ran, DONG Yan-chun, CHEN Xue-guang, WANG Lei, CHU Zhen-hua, ZHANG Jian-xin, HE Ji-ning. Preparing of nanostructured Al2O3-ZrO2-TiO2 composite powders and plasma sprayed nanostructured composite coatings [J]. Vacuum, 2013, 96: 39-45.
[25] BAIA Y, HANA Z H, LI H Q, XUA C, XU Y L, WANG Z, DING C H, YANG J F. High performance nanostructured ZrO2 based thermal barrier coatings deposited by high efficiency supersonic plasma spraying [J]. Applied Surface Science, 2011, 257: 7210-7216.
[26] DAROONPARVAR M, YAJID M A M, YUSOF N M, HUSSAIN M S. Improved thermally grown oxide scale in air plasma sprayed NiCrAlY/Nano-YSZ coatings [J]. Journal of Nanomaterials, 2013, 2013(1): 87-89.
[27] BAKHSHESHI-RAD H, HAMZAH E, LOW H T, KASIRI-ASGARANI, FARAHANY S, AKBARI E, CHO M H. Fabrication of biodegradable Zn-Al-Mg alloy: Mechanical properties, corrosion behavior, cytotoxicity and antibacterial activities [J]. Materials Science and Engineering C, 2017, 73: 215-219.
[28] GNEDENKOV S V, SINEBRYUKHOV S L, MASHTALYAR D V, IMSHINETSKIY I M, GNEDEKOV A S, SAMOKHIN A V, TSVETKOV Y V. Protective composite coatings obtained by plasma electrolytic oxidation on magnesium alloy MA8 [J]. Vacuum, 2015, 120: 107-114.
[29] DURDU S, BAYRAMOGLU S, EMIRTAS D A, USTA M, UCISIK H A. Characterization of AZ31 Mg alloy coated by plasma electrolytic oxidation [J]. Vacuum, 2013, 88: 130-133.
[30] ZHANG Lei, ZHANG Jun-qing, CHEN Cheng-fu, GU Yan-hong. Advances in micro arc oxidation coated AZ31 Mg alloys for biomedical applications [J]. Corrosion Science, 2015, 91: 116-122.
[31] SREEKANTH D, RUMESHBABU N, VENKATESWARU V. Effect of various additives on morphology and corrosion behavior of ceramic coatings developed on AZ31 magnesium alloy by plasma electrolytic oxidation [J]. Ceramics International, 2012, 38: 4607-4615.
[32] CHARLES J, ENGBER G, ERNEST H, ZHEMS H. Thermal Expansion of Al2O3, BeO, MgO, B4C, SiC, and TiC Above 1000 ��C [J]. Journal of the American Ceramic Society, 2006, 42: 300-305.
[33] FIQUET G, RICHET P, MONTAGNAC G. High-temperature thermal expansion of lime, periclase, corundum and spinel [J]. Physics and Chemistry of Minerals, 1999, 27: 103-111.
[34] DAROONPARVAR M. Effects of bond coat and top coat (including nano zones) structures on morphology and type of formed transient stage oxides at pre-heat treated nano NiCrAlY/nano ZrO2-8% Y2O3 interface during oxidation [J]. Journal of Rare Earths, 2015, 33: 983-994.
[35] LIMA R S, DIMITRIEVSKA S, BUREAU M N, MARPLE B R, PETIT A, MWALE F, ANTONIOU J. HVOF-sprayed nano TiO-HA coatings exhibiting enhanced biocompatibility [J]. Journal of Thermal Spray Technology, 2010, 19: 336-347.
[36] GHASEMI R, SHOJA-RAZAVI R, MOZAFARINIA R, JAMALI H. The influence of laser treatment on thermal shock resistance of plasma-sprayed nanostructured yttria stabilized zirconia thermal barrier coatings [J]. Ceramics International, 2014, 40: 347-355.
[37] ZHANG C L, ZHANG F, SONG L, ZENG R C, LI S Q, HAN E H. Corrosion resistance of a superhydrophobic surface on micro-arc oxidation coated Mg-Li-Ca alloy [J]. Journal of Alloys and Compounds, 2017, 728: 518-826.
[38] WU Guo-song, SHANAGHI A, ZHAO Ying, ZHANG Xu-ming, XU Rui-zhen, WU Zheng-wei, LI Guang-yao, CHU P K. The effect of interlayer on corrosion resistance of ceramic coating/Mg alloy substrate in simulated physiological environment [J]. Surface and Coating Technology, 2012, 206: 4892-4898.
[39] GUO Xing-wu, WANG Shao-hua, GONG Jia, GUO Jia-cheng, PENG Li-ming, DING Wen-jiang. Characterization of highly corrosion-resistant nanocrystalline Ni coating electro deposited on Mg-Nd-Zn-Zr alloy from a eutectic-based ionic liquid [J]. Applied Surface Science, 2014, 313: 711-719.
[40] PAK Sung-Nam, JIANG Zhao-hua, YAO Zhong-ping. Fabrication of environmentally friendly anti-corrosive composite coatings on AZ31B Mg alloy by plasma electrolytic oxidation and phytic acid/3-aminopropyltrimethoxysilane post treatment [J]. Surface and Coating Technology, 2017, 325: 579-587.
[41] GUO Lian, ZHANG Fen, SONG Liang, ZENG Rong-chang. Corrosion resistance of ceria/polymethyltrimethoxysilane modified magnesium hydroxide coating on AZ31 magnesium alloy [J]. Surface and Coating Technology, 2017, 328: 121-133.
[42] EZHILSELVI V, BALARAJU J N, SUBRAMANIAN S. Chromate and HF free pretreatment for MAO/electroless nickel coating on AZ31B magnesium alloy [J]. Surface and Coating Technology, 2017, 325: 270-276.
[43] XI Zhong-xian, TAN Cui, XU Lan, YANG Na, LI Qing. Preparation of novel functional Mg/O/PCL/ZnO composite biomaterials and their corrosion resistance [J]. Applied Surface Science, 2105, 351: 410-415.
[44] LI Xia, WENG Zheng-yang, YUAN Wei, LUO Xian-zi, WONG Hoi-man, LIU Xiang-mei, WU Shui-lin, YEUNG K W K, ZHENG Yu-feng, CHU Paul K. Corrosion resistance of dicalcium phosphate dihydrate/poly(lactic-co-glycolic acid) hybrid coating on AZ31 magnesium alloy [J]. Corrosion Science, 2016, 102: 209-221.
[45] CUI Lan-yue, XU Ji, LU Na. In vitro corrosion resistance and antibacterial properties of layer-by-layer assembled chitosan/poly-L- glutamic acid coating on AZ31 magnesium alloys [J]. Transactions of Nonferrous Metals Society of China, 2017, 27: 1081-1086.
[46] WANG S Y, SI N S, XIA Y P, LIU L. Influence of nano-SiC on microstructure and property of MAO coating formed on AZ91D magnesium alloy [J]. Transaction of nonferrous Metals Society of China, 2015, 25: 1926-1934.
[47] PING W, JIANPING L, YOUNCHUN G, ZHONG Y. Growth process and corrosion resistance of ceramic coatings of micro-arc oxidation on Mg-Gd-Y magnesium alloys [J]. Journal of Rare Earths, 2010, 28: 798-802.
[48] WANG Y, WANG X. Role of �� phase during micro arc oxidation of Mg alloy AZ91D and corrosion resistance of the oxidation coating [J]. Journal of Materials Science Technology, 2013, 29: 1129-1133.
[49] DAROONPARVAR M, YAJID M A M, YUSOF N M, BAKHSHESHI-RAD H, HAMZAH E, KAMALI H A. Microstructural characterization and corrosion resistance evaluation of nanostructured Al and Al/AlCr coated Mg-Zn-Ce-La alloy [J]. Journal of Alloys and compounds, 2014, 615: 657-671.
[50] DAROONPARVAR M, YAJID M A M, YUSOF N M, BAKHSHESHI-RAD H, HAMZAH E, MARDANIKIVI T. Deposition of duplex MAO layer/nanostructured titanium dioxide composite coatings on Mg-1%Ca alloy using a combined technique ofair plasma spraying and micro arc oxidation [J]. Journal of Alloys and Compounds, 2015, 649: 591-605.
[51] MANDAL M, MOON A P, DEO G, MENDIS C L, MONDAL K. Corrosion behavior of Mg-2.4Zn alloy micro-alloyed with Ag and Ca [J]. Corrosion Science, 2014, 78: 172-182.
[52] DEJIU S, HAOJIE M, CHANGHONG G, JINGRUI C, GUOLONG L. Effect of cerium and lanthanum additives on plasma electrolytic oxidation of AZ31 magnesium alloy [J]. Journal of Rare Earths, 2013, 31: 1208-1213.
[53] NIU Y, CUI R, HE Y, YU Z. Wear and corrosion behavior of Mg-Gd-Y-Zr alloy treated by mixed molten-salt bath [J]. Journal of Alloys and Compounds, 2014, 610: 294-300.
[54] CUI X J, LIN X Z, LIU C H. Fabrication and corrosion resistance of a hydrophobic micro-arc oxidation coating on AZ31 Mg alloy [J]. Corrosion Science, 2015, 90: 402-412.
[55] SURMENEVA M A, SURMENEV R A. Microstructure characterization and corrosion behavior of a nano-hydroxyapatite coating deposited on AZ31 magnesium alloy using radio frequency magnetron sputtering [J]. Vacuum, 2015, 117: 60-62.
[56] DAROONPARVAR M, MAT YAJID M A, KUMAR GUPTA R, MOHD YUSOF N, BAKHSHESHI-RAD H R, GHANDVAR H. Investigation of corrosion protection performance of multiphase PEO (Mg2SiO4, MgO, MgAl2O4) coatings on Mg alloy formed in aluminate-silicate-based mixture electrolyte [J]. Protection of Metals and Physical Chemistry of Surfaces, 2018, 54: 425-441.
[57] DAROONPARVAR M, MAT YAJID M A, KAY C M, BAKHSHESHI-RAD H, KUMAR GUPTA R, MOHD YUSOF N, GHANDVAR H, ARSHAD A, MOHD ZULKIFLI I S. Effects of Al2O3 diffusion barrier layer (including Y-containing small oxide precipitates) and nanostructured YSZ top coat on the oxidation behavior of HVOF NiCoCrAlTaY/APS YSZ coatings at 1100��C [J]. Corrosion Science, 2018, https://doi.org/10.1016/j.corsci.2018.07. 013.
[58] DAROONPARVAR M, MAT YAJID M A, BAKHSHESHI-RAD H R, YUSOF N M, IZMAN S, HAMZAH E, ABDUL KADIR M R. Corrosion resistance investigation of nanostructured Si-and Si/TiO2- coated Mg alloy in 3.5% NaCl solution [J]. Vacuum, 2014, 108: 61-65.
[59] REN L, LIN X, TAN L, YANG K. Effect of surface coating on antibacterial behavior of magnesium based metals [J]. Materials Letters, 2011, 65: 3509-3511.
[60] GOWRI S, RAJIV R G, SUNDRARAJAN M. Structural, optical, antibacterial and antifungal properties of zirconia nanoparticles by biobased protocol [J]. Journal of Materials Science Technology, 2014, 30(8): 782-790.
����PEO/���ṹZrO2þ�Ͻ�Ϳ��Ŀ������Լ���ʴ��Ϊ
Mohammadreza DAROONPARVAR1,2, Muhamad Azizi MAT YAJID1, Rajeev KUMAR GUPTA2, Noordin MOHD YUSOF1, Hamid Reza BAKHSHESHI-RAD1,3, Hamidreza GHANDVAR1, Ehsan GHASEMI4
1. Department of Materials, Manufacturing and Industrial Engineering, Faculty of Mechanical Engineering, Universiti Teknologi Malaysia, 81310 Johor Bahru, Johor, Malaysia;
2. Department of Chemical and Biomilecular Engineering, Corrosion Engineering Program, The University of Akron, Akron, OH-44325, United States of America;
3. Advanced Materials Research Center, Department of Materials Engineering, Najafabad Branch, Islamic Azad University, Najafabad, Iran;
4. Department of Clinical Sciences, Faculty of Veterinary Medicine, University of Tehran, Tehran, Iran
ժ Ҫ��Ϊ����ǿþ�Ͻ����ʴ�ԺͿ������ԣ��Ȳ��õ�������������(PEO)��þ�Ͻ����Ʊ�һ���ϲ㣬���ÿ�����������Ϳ(APS)�Ʊ����ṹZrO2����Ϳ�㡣���õ绯ѧ�����о�Ϳ����Ʒ�ĸ�ʴ��Ϊ��������֬��ɢ��������д˾���ԭ���־��������ۣ�������Ϳ����Ʒ���жԱȡ���PEOͿ�����Ϳ��þ�Ͻ���ȣ�PEO/����ZrO2Ϳ����Ʒ�ĸ�ʴ�����ܶ���ͣ���ɴ���������ߣ���λ�Ǻ��迹ģ����ߡ�PEO���Ϳ�㱻����ZrO2����Ϳ����ȫ�ܷ⣬�ܹ������ӻ���ʴ��������þ�Ͻ����Ǩ�ƣ��������þ�Ͻ���ģ����Һ(SBF)�е���ʴ�ԡ����⣬PEO/����ZrO2Ϳ��Ŀ�������Ҳ����PEOͿ�����Ϳ��þ�Ͻ���������ZrO2������ͨ��������ϸ��Ĥ�������˴˾����������ʡ�
�ؼ��ʣ�þ�Ͻ��մɣ�Ϳ����ϣ�����֯��ɨ��羵
(Edited by Xiang-qun LI)
Corresponding author: Mohammadreza DAROONPARVAR; E-mail: mr.daroonparvar@yahoo.com, re_dr7@yahoo.com
DOI: 10.1016/S1003-6326(18)64799-5
Abstract: Plasma electrolytic oxidation (PEO) was developed as a bond coat for air plasma sprayed (APS) nanostructure ZrO2 as top coat to enhance the corrosion resistance and antibacterial activity of Mg alloy. Corrosion behavior and antibacterial activities of coated and uncoated samples were assessed by electrochemical tests and agar diffusion method toward Escherichia coli (E. coli) bacterial pathogens, respectively. The lowest corrosion current density and the highest charge transfer resistance, phase angle and impedance modulus were observed for PEO/nano-ZrO2 coated sample compared with those of PEO coated and bare Mg alloys. Nano-ZrO2 top coat which has completely sealed PEO bond coat is able to considerably delay aggressive ions transportation towards Mg alloy surface and significantly enhances corrosion resistance of Mg alloy in simulated body fluid (SBF) solution. Moreover, higher antibacterial activity was also observed in PEO/nano-ZrO2 coating against bacterial strains than that of the PEO coated and bare Mg alloys. This observation was attributed to the presence of ZrO2 nanoparticles which decelerate E. coli growth as a result of E. coli membranes.


